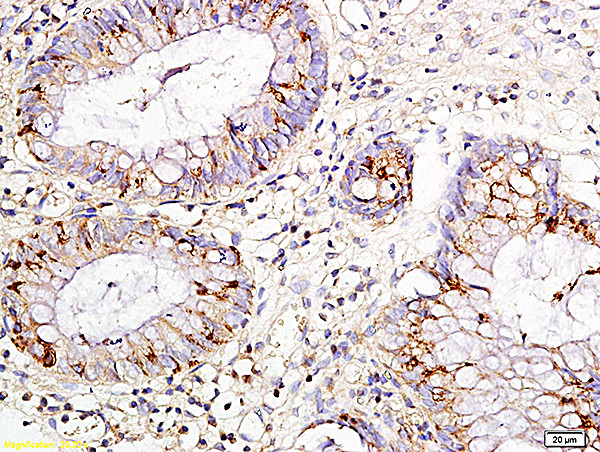
IL-15 Antibody in Immunohistochemistry (Paraffin) (IHC (P))

Search
Bioss
IL-15 Polyclonal Antibody
{{$productOrderCtrl.translations['antibody.pdp.commerceCard.promotion.promotions']}}
{{$productOrderCtrl.translations['antibody.pdp.commerceCard.promotion.viewpromo']}}
{{$productOrderCtrl.translations['antibody.pdp.commerceCard.promotion.promocode']}}: {{promo.promoCode}} {{promo.promoTitle}} {{promo.promoDescription}}. {{$productOrderCtrl.translations['antibody.pdp.commerceCard.promotion.learnmore']}}
产品信息
BS-1829R
种属反应
宿主/亚型
分类
类型
抗原
偶联物
形式
浓度
规格
纯化类型
保存液
内含物
保存条件
运输条件
靶标信息
IL-15 (Interleukin 15 ) is a cytokine that regulates T and natural killer cell activation and proliferation. IL-15 and IL-2 share many biological activities as both have been found to bind common hematopoietin receptor subunits, and may compete for the same receptor, and thus negatively regulate each other's activity. The number of CD8+ memory cells is shown to be controlled by a balance between IL-15 and IL-2. IL-15 induces the activation of JAK kinases, as well as the phosphorylation and activation of transcription activators STAT3, STAT5, and STAT6. In mouse, studies suggest that IL-15 may increase the expression of apoptosis inhibitor Bcl-xL, possibly through the transcription activation activity of STAT6, and thus prevent apoptosis. IL-15 plays an important role in the growth and differentiation of T and B lymphocytes, natural killer cells, macrophages, and monocytes as well as activation of a number of important intracellular signaling molecules. As such, IL-15 could be essential for the immune responses, allograft rejection, and the pathogenesis of autoimmune diseases. Further, IL-15 is a widely expressed pro-inflammatory cytokine and has been shown to play a role in several inflammatory disorders, including rheumatoid arthritis, psoriasis and pulmonary inflammatory diseases. Emerging data suggest that IL-15 may serve as a good therapeutic target, as there appears to be a beneficial effect of IL-15 neutralization in models of psoriasis and diabetes.
仅用于科研。不用于诊断过程。未经明确授权不得转售。
篇参考文献 (0)
生物信息学
蛋白别名: HTLV-I R-IL-15 fusion gene; il 15; IL-15; IL15; ILN; Interleukin; Interleukin-15; Interleukin15; lymphokine; M-IL-15; MGC9721; unnamed protein product
基因别名: AI503618; IL-15; IL15
UniProt ID: (Human) P40933, (Mouse) P48346, (Rat) P97604
Entrez Gene ID: (Human) 3600, (Mouse) 16168, (Rat) 25670